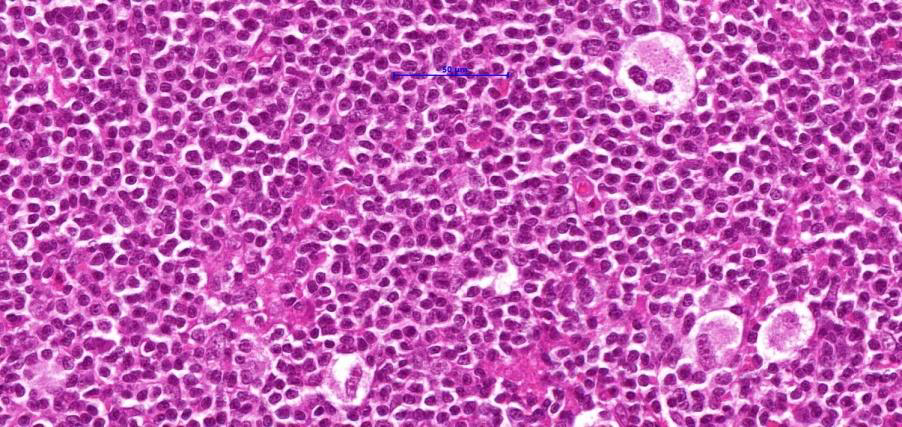
term image
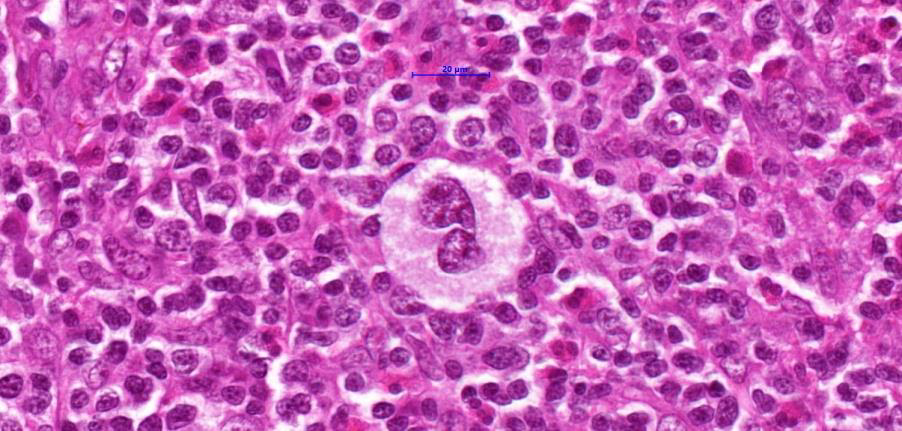
term image
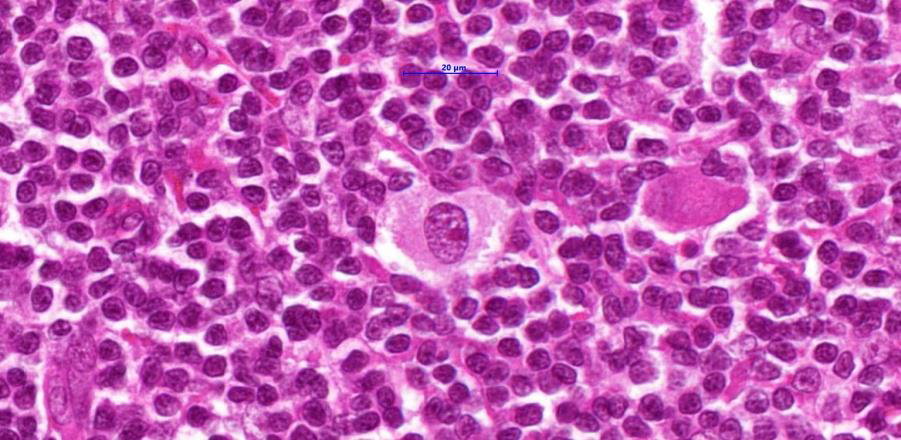
term image
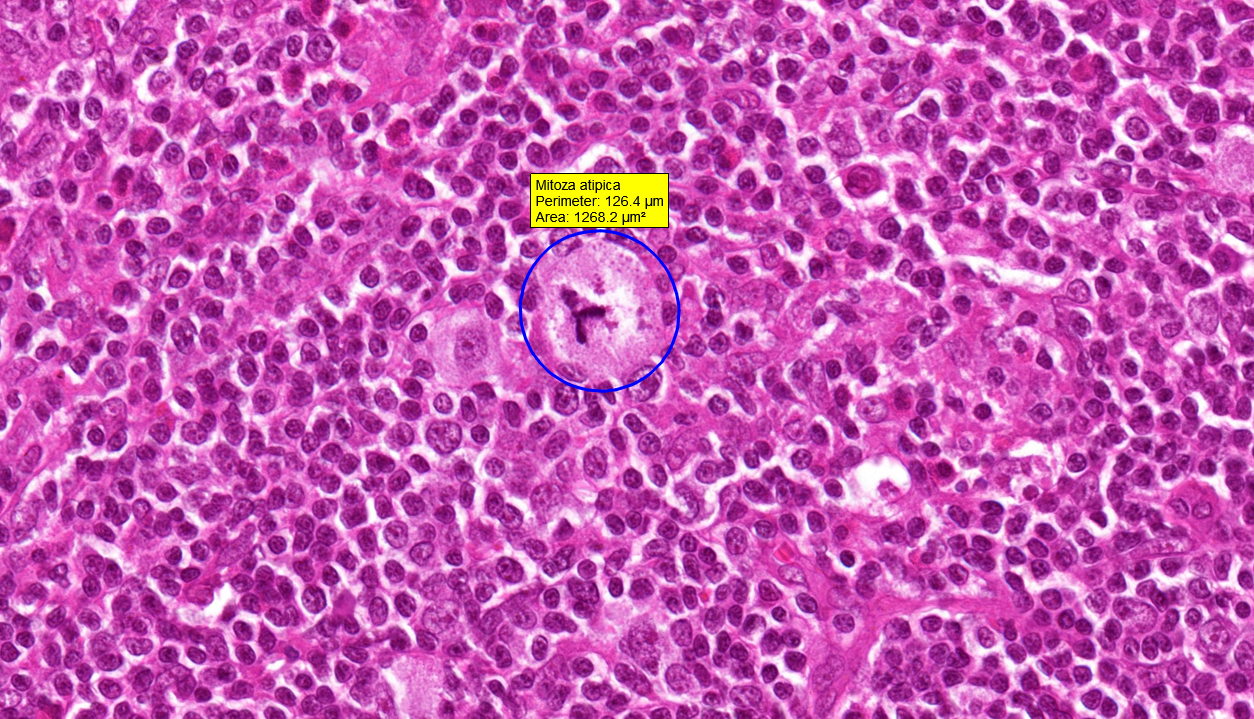
term image

Malignant tumors
1/36
Earn XP
Description and Tags
Macro and micro
Name | Mastery | Learn | Test | Matching | Spaced | Call with Kai |
|---|
No analytics yet
Send a link to your students to track their progress
37 Terms

malignant of uterus

Grawitz tumor

basal cell carcinoma macro

Basal cell carcinoma micro

Basal cell carcinoma irregular islets of malignant cells in dermis

Basal cell carcinoma slit like retractions

Basal cell carcinoma picket fence cells in the periphery, and irregular cells in the centre

Basal cell carcinoma, malignant bad islets

squamous cell carcinoma of the lip

Squamous cell carcinoma of the uterus

Keratinised squamous cell carcinoma, plaques and lobules of malignant cells ,
readily recognizable as prickle cells

Keratinised squamous cell carcinoma, epithelial pearls

Keratinised squamous cell carcinoma, polygonal cells, with eosinophilic cytoplasm and pleomorphism x and epithelial pearls in

Keratinised squamous cell carcinoma, perineural invasion

Keratinised squamous cell carcinoma,

Adenocarcinoma of the rec*um

Adenocarcinoma of stomach

adenocarcinoma with pseudoglands

adenocarcinoma, pseudoglands lined by one or more layers
of pleomorphic malignant cells
atypical mitoses

adenocarcinoma

pleomorphic malignant cells in pseudoglands adenocarcinoma

sarcoma of the thigh

Fibrosarcoma, herringbone pattern in atypical spindle cells

Fibrosarcoma, areas of necrosis 1 and hemorrhage 2, fibroblasts with hyperchromatic and uneven, big nuclei

Undifferentiated pleomorphic sarcoma

Undifferentiated pleomorphic sarcoma, necrosis green and hemorrhage

Undifferentiated pleomorphic sarcoma, necrosis green and hemorrhage
Hodgkin lymphoma, Reed-Sternberg cell
Hodgkin lymphoma, Reed-Sternberg cell
Hodgkin lymphoma, Hodgkin cell
atypical mitosis in Hodgkin lymphoma

Hodgkin lymphoma

Lymph node metastases of adenocarcinoma

Lymph node metastases of adenocarcinoma

Lymph node metastases, we can see malignant pseudoglands replacing normal tissue

Lymph node metastase of adenocarcinoma